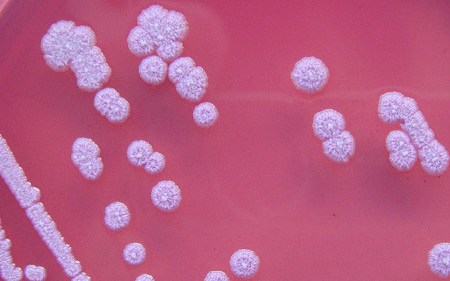

Categoria: Guido G. Gattai
Consulente filosofico tradotto in varie lingue e scrittore satirico, Guido Giacomo Gattai è fondatore del movimento hyronista.
contatti


AMORE: segreti, misteri e bugie

IL MAESTRO DI TIZIANO TERZANI: Victor Zorza, morte e rinascita

FILOSOFIA ZERO

QUEL BASTARDO DEL MIO DAIMON

LE MECCANICHE DELL’AMORE

PERCHÉ LE DICHIARAZIONI D’AMORE NON FUNZIONANO MAI

CONSUMISMO VS SCIENTISMO

LA BANALITÀ DEL BENE

LA BIGLIA

Bomba Nonviolenta e Artificazione Interruttiva

Estinti Distinti – 03

Estinti Distinti – 02

Estinti Distinti – 01

SGRETOLATA

HO CONOSCIUTO V, E IL 7 OTTOBRE CI SALVERÀ

NON C’È BISOGNO CHE QUALCUNO COMPLOTTI PERCHÉ CI SIANO I COMPLOTTI

Inversione satanica del consumismo

Perché dovremmo essere tutti cattolici e vegani

Perché la psicologia non ci salverà in alcun modo

LOTTA NELLE STRADE: WELLING E DEMERCIFICAZIONE

ACCORGIMENTI PER CAMBIARE IL MONDO

LA MASCHERA DI MILGRAM

SIAMO TUTTI EGOISTI? NO, ASSOLUTAMENTE NO!

BAMBINIZZAZIONE E PEDOCRAZIA

LA CONSAPEVOLEZZA CULTURALE

SI DEVE, DEVO, VOGLIO, HO VOGLIA, MI VA

CREATORI E RIPARATORI

… E TU?

CARO MONDO

TRASFORMAZIONE

LA LISTA DELLA SPESA MORALE

Consumismo – Fase Satanica

Il fascismo eterno di Umberto Eco

CHE FINE HA FATTO L’ALTERNANZA?

MEDEA VS. CORNELIA

INVASIONE

MASCHILISMO INTELLIGENTE

Neuroni a morte!

Il senso della vita è: INSIEME. E non solo.

LA TENTAZIONE DEL DEMONIO

ANCELLA SÌ, PERÒ…

L’anti-complottismo come malattia: adunafobia e sustafobia

COME RICONOSCERE UNA BUFALA

LA GUERRA DELLE UOVA

PREACHER

MI MANCANO I NEGRI – VIVA LA CARTA E LA LIBERTÀ!

RETTILIANI: CI SPERO!
NUOVA MALATTIA MORTALE SCOPERTA!
